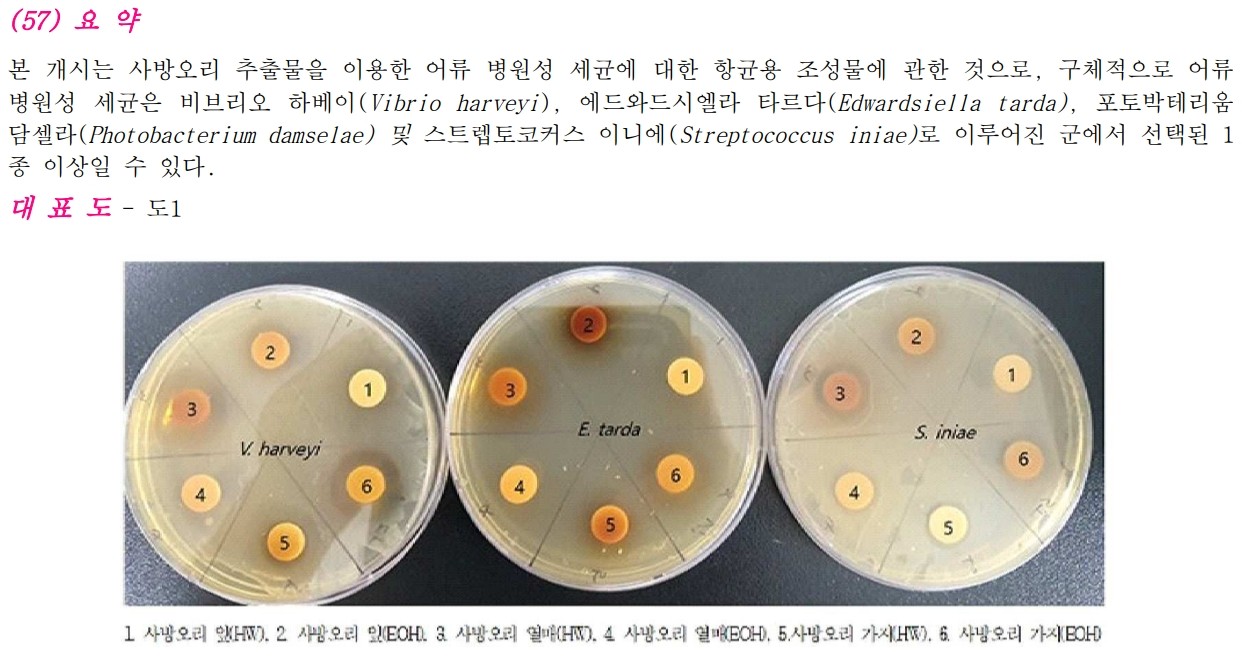

상세내용은 아래 링크를 클릭하세요
사방오리 추출물을 유효성분으로 포함하는, 어류 병원성 세균에 대한 항균용 조성물
제주한의약연구원
| 담당부서 | 관리자 | 출원(등록)번호 | 1020250025950 |
|---|---|---|---|
| 작성일 | 2026.01.08 | 출원(등록)일 | 2023.08.16 |
| 현재상태 | 국내 | 성과구분 | 출원 |
상세내용은 아래 링크를 클릭하세요
사방오리 추출물을 유효성분으로 포함하는, 어류 병원성 세균에 대한 항균용 조성물
- 이메일 : mail@jikom.or.kr
- 내용문의 : 064-702-9772